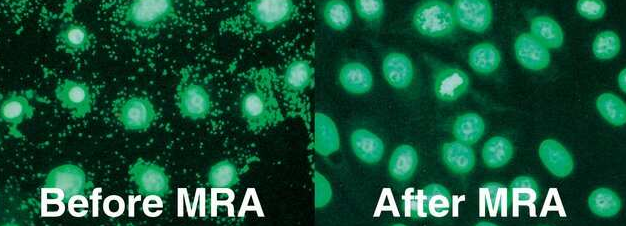

MP Biomedicals, the leader in bead beating, can provide a large range of instruments and tube holders for all your requirements. We can offer you the best solutions with which to achieve reliable results.
FastPrep™ homogenizers grind and pulverize samples through simultaneous beating of specialized lysing matrix beads. These systems, together with interchangeable tube holders, allow unique flexibility in terms of sample size and temperature (ambient or cryogenic conditions). Combined with the widest selection of lysing matrix materials and complete isolation kits, FastPrep will handle your most difficult samples including plant, root, soil, waste water, skin, tissue, seeds, and feces, as well as inorganic or mineral samples, within a few seconds or less…every time.

Low Throughput/Low Volumes
High Throughput/High Volumes
Experience high-speed lysis on the most resistant samples with the FastPrep-24 5G™, able to pulverize or lyse samples quickly in 40 seconds or less. One of the best complete solutions available, FastPrep-24 5G™ instruments, together with FastPrep™ kits as well as lysing matrix compositions and tubes, are optimized to provide the highest quality results from any sample type.

Experience high speed lysis on the most resistant samples with the FastPrep-24™ 5G.
Most powerful - Highest speed available improves the quality and yield of the resultant analyte.
Exclusive software & touchscreen - Intuitive, easy touch screen programming or choose from 70 recommended pre-programmed optimized application protocols.
Most versatile - Largest variety of interchangeable tube holders, process from 0.5mL to 250mL under ambient or cryogenic conditions.
MP Biomedicals offers the widest available selection of tube holders to best meet your needs in sample preparation. Our sample holders allow for tube sizes ranging from 2 to 250mL and are built for durability under ambient and cryogenic conditions. During mechanical lysis, the temperature within the tube can increase and can cause damage to the molecules in your sample. The cooling chamber and dry ice of our cryoadapters thus:
Tube holders made from metal are ideally suited for work with highly infectious, pathogenic, or otherwise biologically hazardous samples. They can withstand temperatures up to 450°C, allowing for sterilization by pyrolysis or autoclaving. As such, pathogens including bacteria, viruses, fungi, parasites, viroids, and prions can be effectively eliminated. All-metal tube holders are also safe to use with most laboratory detergents and sterilization solutions, ensuring easy care and maintenance.
Get the best results from your sample preparation by using MP Biomedicals Lysing Matrix in combination with a FastPrep™ instrument.
With over 16 unique components, FastPrep™ Lysing Matrices are impact-resistant tubes containing specific beads to meet any of your lysing, grinding or homogenization needs. They are available in 2mL, 4.5mL, 15mL, 50mL, and 250mL sizes, as well as in 96 deep well plates.

Although they are designed to be used with a FastPrep™ homogenizer, the standard size of the tubes allows their use with many other bead beaters.

MP Biomedicals supplies a complete range of organic, spin column, and magnetic bead based extraction kits for the isolation of high quality DNA and RNA. All kits included in the FastPrep™ product line contain optimized Lysing Matrix tubes for the sample homogenization step and reagents for further DNA, RNA or protein isolation. Yields and processing times are greatly enhanced through the use of FastPrep™ homogenizers.

Lysing Matrix E contains 1.4 mm ceramic spheres, 0.1 mm silica spheres, and one 4 mm glass bead. Used to grind soil and other enviromental samples.

FastDNA™ SPIN Kit for Soil is used for rapid isolation of PCR-ready genomic DNA from any environmental sample.
The MPure-32™ aNAP System is a fully automatic platform for magnetic reagent assays. It can process up to 32 samples simultaneously within a short period of time (around 40 to 60 minutes) while still achieving scientific and diagnostic requirements within a safe operating procedure. Besides its capability to extract nucleic acids with high purity and yield, the MPure-32™ aNAP System can also be used for protein extraction or separation of cells. It is easy to use for pre-filled or self-filled reagent plates.
Magbeads FastDNA and FastRNA kits are using magnetic beads technology with high binding capacity and selectivity for DNA and RNA to isolate nucleic acids. They include Lysing Matrix tubes for a thorough and rapid grinding of the sample.
High-quality nucleic acids isolated with the MagBeads Kits are suitable for a broad range of applications including real-time PCR and next-generation sequencing

The MPure-32 aNAP System is intended to be used in combination with MP Biomedicals DNA/RNA extraction kits to extract the DNA/RNA from clinical/non-clinical specimens. This instrument can be used to support sample preparation work in scientific research and in-vitro diagnostic testing.
One of the major issues in dealing with mammalian cell culture is infection due to mycoplasma. The presence of mycoplasma can alter many cellular processes and cause malfunctioning of cells in proliferation, protein synthesis, DNA transfection, etc. MP Biomedicals™ offers a complete solution for mycoplasma contamination in cell culture, from prevention, rapid detection (20 min), and sensitive detection (10CFU/mL) to effective removal (fast and low cytotoxicity).
Successfully treat infected cell culture with MRA, the most reliable solution for mycoplasma removal and prevention, ensuring quality results, including:
Trusted by labs worldwide and available exclusively from MP Biomedicals, 7X™ solutions have been used for over 50 years to provide safe and effective cleaning of laboratory benches and apparatus whenever a high degree of cleanliness is required. They are of particular value in cell culture laboratories where they have a number of advantages:
7X™ cleaning solutions should be of particular value in cell culture laboratories where
Fetal bovine serum (FBS) is widely used as a serum-supplement for in vitro cell culture media. FBS promotes healthy cell growth by providing an undefined mixture of nutrients, such as proteins, attachment factors, growth factors, lipids and hormones. However, due to its undefined nature, FBS can lead to unexpected and undesired stimulation of cells. There is also biorisk from animal protein or pathogen contamination, including risk of bovine spongiform encephalopathy (BSE). To avoid these concerns, MP Biomedicals™ has launched FastGro™, a fully chemically defined FBS replacement for cell culture use. It allows culturing of a wide range of cells in vitro without the use of serum or any animal or human derived compounds.
The ultimate in consistency & accuracy, MP Biomedicals is well known for providing high-quality growth media in a variety of formulations for every molecular biologist. We specialize in formulations for yeast and bacteria and offer more than a thousand recipes and variations. MP Biomedicals is the only source of encapsulated growth media. Our patented media capsules eliminate the waste, inaccuracies, and mess associated with weighing out bulk powder. Each recipe is subjected to extensive quantitative testing, and is Molecular Biology Certified™ through qualitative tests such as cell density and plasmid yield. Easy to use. Simply drop the capsule in water and autoclave. No Mess. No Cleanup.
Mycoplasma Removal Agent (MRA) is a derivative of the quinoline family of antibiotics and eliminates mycoplasma contamination in cell cultures by inhibiting mycoplasma DNA gyrase.

Safe, effective cleaning solutions for glass and plastic labware.

Formulations for the E. coli growth media known as LB Medium typically contain 10g of tryptone and 5g of yeast extract per liter, and LB Medium contains 10g NaCl per liter
DSS is a polyanionic derivative of Dextran offered at the highest quality and purity, and in the most reproducible form. It is a potent intestinal inflammation reagent and the gold standard in colitis research.
DSS is a polyanionic derivative of Dextran offered at the highest quality and purity, and in reproducible form.
DSS is one of the most common and effective compounds used to trigger colitis in mice and rats when administered in drinking water. The DSS colitis model has also been used extensively to study colon cancer.
Because of its high efficacy, MP Biomedicals™ Premium DSS (MW = 36,000–50,000) is one of the most widely used DSS products in the scientific literature.
MP Biomedicals™ Premium DSS technical advantages:

MP Biomedicals develops, produces, and distributes more than 50,000 references of reagents, kits and instruments as well as services, and is one of the only companies in the industry to offer a comprehensive portfolio for life science, manufacturing, and diagnostic.